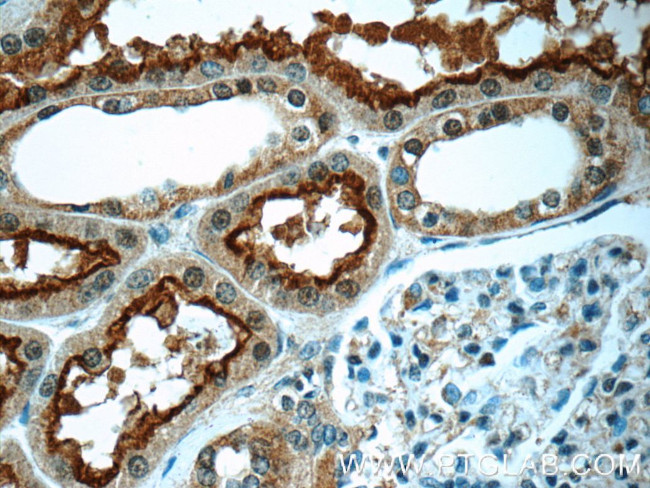
OCTN2 Antibody in Immunohistochemistry (Paraffin) (IHC (P))

Search
Proteintech
OCTN2 Polyclonal Antibody
{{$productOrderCtrl.translations['antibody.pdp.commerceCard.promotion.promotions']}}
{{$productOrderCtrl.translations['antibody.pdp.commerceCard.promotion.viewpromo']}}
{{$productOrderCtrl.translations['antibody.pdp.commerceCard.promotion.promocode']}}: {{promo.promoCode}} {{promo.promoTitle}} {{promo.promoDescription}}. {{$productOrderCtrl.translations['antibody.pdp.commerceCard.promotion.learnmore']}}
产品信息
16331-1-AP
种属反应
已发表种属
宿主/亚型
分类
类型
抗原
偶联物
形式
浓度
规格
纯化类型
保存液
内含物
保存条件
运输条件
产品详细信息
Immunogen sequence: MRDYDEVTA FLGEWGPFQR LIFFLLSASI IPNGFTGLSS VFLIATPEHR CRVPDAANLS SAWRNHTVPL RLRDGREVPH SCRRYRLATI ANFSALGLEP GRDVDLGQLE QESCPDGWEF SQDVYLSTIV TEWNLVCEDD WKA (1-142 aa encoded by BC012325)
靶标信息
Carnitine (b-hydroxy-g-trimethylaminobutyrate) is a small, highly polar compound that aids in the b-oxidation of long-chain fatty acids. Organic cation/carnitine transporters (OCTN) assist in the elimination of cationic compounds, including xenobiotics, and transport carnitine for reabsorption in the kidney. Similar to organic cation transporters (OCT), OCTN proteins localize to the plasma membrane of epithelial cells. OCTN1 is expressed in kidney, trachea, bone marrow and fetal liver. OCTN2 is abundantly expressed in kidney, skeletal muscle, placenta and heart. OCTN3 is strongly expressed in testis and weakly expressed in kidney. The gene encoding human OCTN1 maps to chromosome 5 and the gene encoding human OCTN2 maps to chromosome 5q31. Mutations in the gene encoding OCTN2 leads to systemic carnitine deficiency (SCD), an autosomal recessive disorder characterized by cardiomyopathy, skeletal myopathy, lethargy, hypoglycemia and hyperammonemia.
仅用于科研。不用于诊断过程。未经明确授权不得转售。
生物信息学
蛋白别名: CT1; high-affinity carnitine transporter; high-affinity sodium dependent carnitine cotransporter; High-affinity sodium-dependent carnitine cotransporter; integral membrane transport protein; juvenile visceral steatosis; OCTN2VT; Organic cation/carnitine transporter 2; S22A5; solute carrier family 22 (organic cation transporter), member 5; Solute carrier family 22 member 5; solute carrier family 22, member 5; systemic carnitine deficiency; unnamed protein product; UST2r
基因别名: CDSP; CT1; jvs; Lstpl; OCTN2; SLC22A5; UST2r
UniProt ID: (Human) O76082, (Mouse) Q9Z0E8, (Rat) O70594
Entrez Gene ID: (Human) 6584, (Mouse) 20520, (Rat) 29726